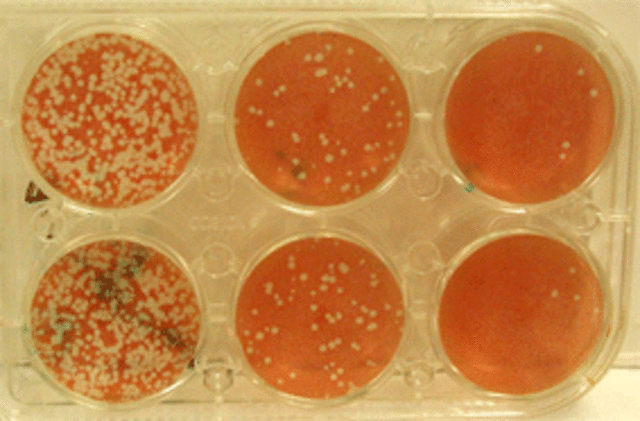
Bergmann

-
Lanzaron la teoria coniocida como la totipotencia
-
Establece que las celulas son autosuficientes
-
Inicio cultivos a partir del mesofilo de celulas muy diferenciadas
-
Logro el aislamiento de embriones inmaduros de cruciferas
-
Tuvieron Exito al cultivar in invito tejido animal y humano.
-
establecio el medio de cultivo para la germinacion asimbiotica de semillas de orquideas.
-
Cultivaron Apices de raicez de frijol,maiz y tomate y mantenerlas en cultivo durante un tiempo prolongado.
-
Realizo ensayos utilizando como explante el cambium de arboles y arbustos.
-
Lograron el crecimiento indefinido de tejido de raiz.
-
Utilizaron agua de coco para el cultivo de embriones.
-
Cultivo de embrioneson agua de coco
-
Emplearon por primera vez el agua de coco para el cultivo de embriones en Datura.http://www.cocotap.com/nutrition.htm
-
Obtuvo lops primeros cultivos de tabaco invitro para estudiar la formacion de vastagos adventicios
-
Obtuvo plantas completas a partir de apices caulinares de lupinusy tropeaolum
-
Logro cultivar por primera vez tejido de agalla de coprona libre de bacteria inductora en un medio definido que contenia sacarosa y sales inorganicas en ausencia de hormonas endogenas.
-
Cultivo gametofitos masculinos zamia fioridiana demostrando que el polen puede desarrollarse en un medio de cultivo adecuado
-
Obtuvo por primera vez la regeneracion de organos a partir de callos en sequioia sempervirens.
-
Obtuvo la regereneracion de organos a partir de callos en sequoia sempervirerns
-
-
Demostraron que en determinadas partes de las plantas, los tejidos meristematicos tenian la capacidad de desarrollar plantas completas en condiciones in vitro.
-
Obtuvo por primera vez callo aploide de Ginkgo biloba a partir del polen.
-
Establecieron la estructura molecular de doble elices del acido desoxirribonucleico (ADN) .
-
Utilizaron por primera vez cultivos nodriza de celulas aisladass para la regeneracion de plantas .
-
Identifico la kinetina como sustabncia regualadora de la division celularel cual constituyo un nuevo impulso para el desarrollo de sistemas in vitro
-
Reporataro el contfrol de la formacion de brotes y raices en tabaco utlilizandio diferentes concentraciones de auxinas y citoquininas .
-
la demostracion de los cultivos celulas iniciados a partir de raices de daucus carota
-
obtuvieron la regeneracion in vitro de embriones somaticos a partir de nucela y ovulos de citrus spp
-
Desarrollo el proceso de filtracion de sustancias celulares y aislamiento de celulas mediante el plaqueo.
-
Logro la propagacion vegetativa en orquideas utilizando el cultivo de meristemo.
-
Utilizo la enzima celulosa obtenida del hongo myrothecium verrucaria para realizar la degradacion de la pared celular.
-
Reporto por primera vez la fertilizacion in- vitro de ovulos en papaver somniferum.
-
Logro la regeneracion de tallos y vastagos a partir de callos en populus tremuloides .
-
Consi|dero que cada celula vegetal viviente capaz de generar estimulos puede dividirse en meristemoide potencialmente capaz y geneticamente apto para dividirse y desarrollarse como cualquier celula y formar estructuras multicelulares.
-
estudiaron los mecanismos presentes en la funcion espontanea, al ser degradada la pared celular, las conexiones plasmodesmales en las celulas alargadas eventualmente se expanden permitiendo el paso de organelos a celulas contiguas.
-
Reportaron la primera hibridacion interespecifica de dos especies de nicotiana mediante la fusion de protoplastos
-
Desarrollaron en suiza el arroz dorado al insertar dos genes de narcizo y un gen bacteriano, realizando las cuatro atapas neceasrias para la produccion de betacaroteno.
Plan projects on a visual timeline
Map milestones, phases, deadlines, and key events in one place so the sequence is easier to see and share. Timetoast is a timeline maker for work, school, research, and stories.